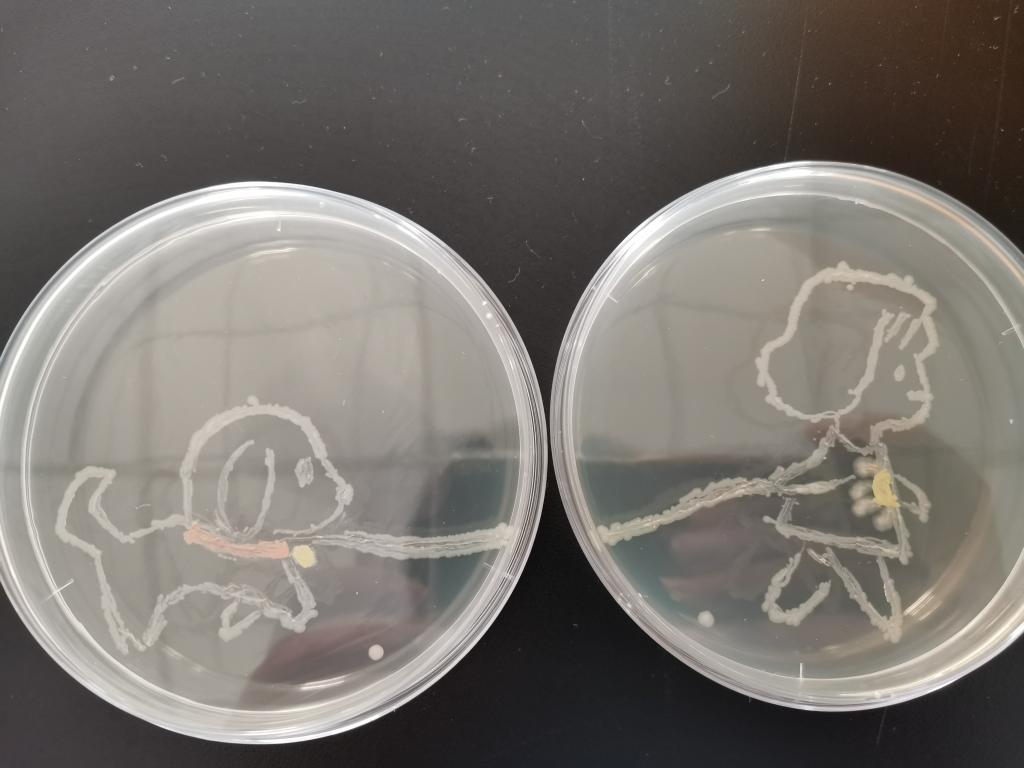

2019年12月13日下午,由beat365主办、微生物与免疫学教研室承办的第三届“形态学实验技能”大赛圆满落下帷幕。
此次“形态学实验技能”大赛分为初赛和决赛两个赛程,初赛以剪纸造型紫外杀菌的形式举行,规定比赛时间为15分钟,要求参赛选手在掌握密集划线的基础上,以特色剪纸造型覆盖后紫外杀菌。决赛以营养琼脂平皿为画布,接种针为画笔,细菌为颜料作画。比赛过程中,选手们表现镇定,自信果断,为了自己的目标画作奋力拼搏。经过决赛激烈的交锋,最终产生了一、二、三等奖,其中一等奖获得者为2018级护理学3班刘亚林同学。

比赛现场

刘亚林同学获一等奖
本次实验技能大赛旨在丰富同学们的微生物学知识,提高同学们的实验技巧和科学文化素质,是一场智慧的交锋、一次思维的碰撞。比赛过程轻松而精彩,紧张而令人留恋,使同学们在挑战与愉悦的氛围中学习知识、充实生活。
参赛作品展示

参赛作品展示

参赛作品展示